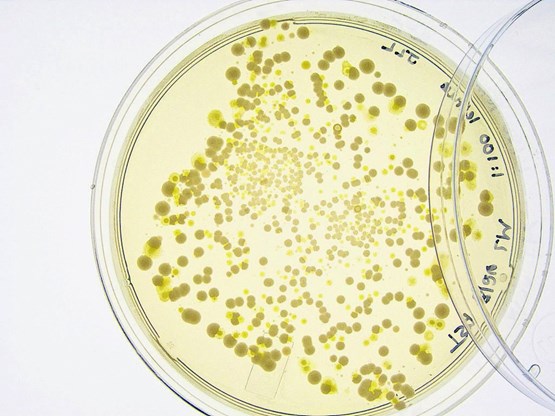

Taxes empoisonnantes
Biocides – Destinés à neutraliser les organismes nuisibles, ces produits chimiques distribués en Suisse s’avèrent surtout toxiques pour les PME: taxes élevées, entraves et bureaucratie.
Les biocides englobent une famille de produits chimiques ou biologiques destinés à repousser, neutraliser ou détruire des organismes nuisibles (rats, insectes, champignons, microbes, etc.). Bien que «bio» + «cide» signifie littéralement «qui tue la vie», certains biocides sont perçus comme des produits de désinfection (de l’eau, par exemple) ou de protection (du bois, etc.). Mais cette grande famille de biocides empoisonne surtout les petites et moyennes entreprises, et cela pour plusieurs raisons.
Emoluments et entraves dans le radar confédéral
Poisons, les biocides sont donc soumis à une procédure d’autorisation. Pour chaque procédure d’un biocide en Suisse, il en coûte environ 1000 francs. Toutefois, la majorité des biocides en circulation proviennent de l’UE où, là aussi, ils sont considérés comme poisons et donc également soumis à autorisation.
Logiquement, si un biocide est autorisé sur l’ensemble du territoire de l’UE, pourquoi ne le serait-il pas également en Suisse? Oui, c’est prévu par la législation, mais pas gratuitement. La procédure coûte au moins 5000 francs, soit 4000 francs de plus que les émoluments d’une autorisation ordinaire! Ce n’est ni plus ni moins qu’une entrave au commerce.
Enquête et éviction du marché
«Pas assez cher» estime pourtant la Confédération qui, en janvier, a mandaté un institut de sondage bâlois pour prendre la température auprès des entreprises concernées. Nos fonctionnaires fédéraux partent du principe qu’il est parfaitement normal de facturer aux entreprises une moyenne de 7500 francs (fourchette de 5000 à 10 000 francs) pour une simple reconnaissance de l’autorisation européenne déjà existante.
Si, en Suisse, chaque reconnaissance d’autorisation UE revient à 7500 francs et que l’on répertorie 5000 biocides sur le marché, dont l’autorisation devra être renouvelée en 2015, la facture s’élèverait à 37 500 000 francs! Pour les PME en particulier, la charge est trop lourde et risque de les évincer du marché.
Sans parler de l’enquête, un questionnaire de 9 pages avec 26 questions! Outre les biocides employés, les entreprises doivent également mentionner leur prix et modes de paiement, la source des informations sur les produits et si elles fréquentent des séances d’information! Quant à la question de savoir si la taxe de 7500 francs ne leur semble pas «trop basse», on se demande encore, si c’est de l’humour ou de l’ironie.
Invasion de règlementations
Ce qui est sûr, en revanche, c’est la volonté de règlementer sans limite. Voici deux exemples:
Le premier concerne les «bâtonnets insecticides» pour plantes, autorisés dans l’UE, mais interdits en Suisse. Une action en justice est intentée contre cette décision, mais visiblement sans grande chance de succès. Ainsi, d’un côté on interdit ce qu’on a payé et d’un autre, on doit encore payer pour tenter une levée de l’interdiction...
Le second exemple touche les adaptations liées au nouveau système d’harmonisation global de classification et d’étiquetage (SHG) des biocides qui, sous le régime de l’OPBio révisée (RS 813.12), sont entrées en vigueur en Suisse le 15 juillet 2014. Ainsi, les détenteurs d’autorisations basées sur l’ancien système de classement («orange/noir») avaient jusqu’au 31 décembre 2014 pour déposer une demande de conformité (SHG, art. 35 et 38 de la RS). Voilà encore un élément sans intérêt, mais sollicitant de gros efforts.
L’attitude suisse à l’égard des biocides n’est qu’un exemple parmi de nombreuses «micro règlementations» que l’Etat introduit sous les radars du monde politique et à l’insu de la population. Pourtant, ces règlementations ankylosent l’économie. Rien que sur le «droit de l’environnement», le Conseil fédéral chiffre le potentiel d’économie du coût de la règlementation à 1 milliard de francs! Ah, s’il passait enfin à l’action!
Henrique Schneider, usam